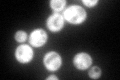
YAL036C
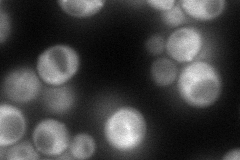
YAL036C
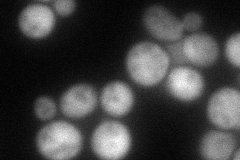
YAL036C
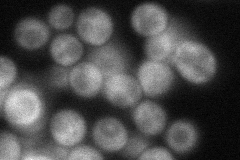
YAL036C
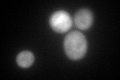
YAL036C
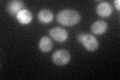
YAL036C

View description
Member of the DRG family of GTP-binding proteins; associates with translating ribosomes; interacts with Tma46p, Ygr250cp, Gir2p and Yap1p via two-hybrid
Localization:
Intensity:
Fold change:
Significance:
-
C’ GFP library in SD
cytosol109.13 -
N' NOP1pr-GFP in SD
cytosol,punctate105.443 -
N' TEF2pr-mCherry in SD
cytosol81.7894 -
N' NATIVEpr-GFP in SD
cytosol50.3317 -
N' TEF2pr-VC and Cyto-VN in SD

#N/A0 -
C’ GFP library in SD+DTT
cytosol91.010.83No -
C’ GFP library in SD+H2O2

cytosol107.260.98No -
C’ GFP library in Starvation Media
cytosol87.170.79No -
C’ GFP library on the background of Pup2-DaMP

cytosol -
C’ GFP library on the background of CCT mutant

cytosol106.1850.972841No
